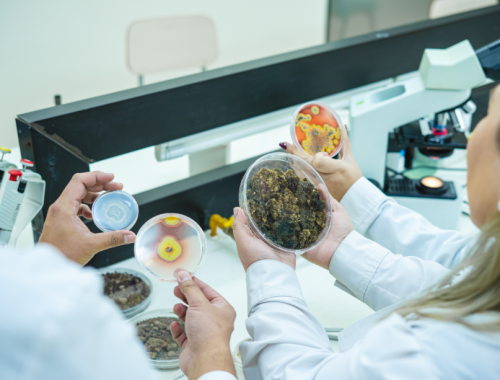

HÁBITOS ALIMENTICIOS: Dieta y su impacto en la salud bucal, claves para una sonrisa saludable.
- Odontólogo de la Universidad de Talca explicó la importancia que tiene la alimentación para prevenir la caries y el desgaste dental.
Septiembre es un mes que suele ser de excesos en la alimentación de los chilenos, con un importante consumo de sodio incluido en las distintas preparaciones típicas, pero también con una alta ingesta de azúcar por las bebidas ácidas y dulces.
Este último aspecto es el que más preocupa a los odontólogos, puesto que los alimentos con alto contenido de azúcares, están directamente relacionados con un mayor riesgo de caries. En el caso de las bebidas, éstas pueden causar desgaste dental por el efecto de los ácidos en los dientes y la acción mecánica de morder.
Así lo indicó el cirujano dentista y académico de la Facultad de Odontología de la Universidad de Talca, Sebastián Valdés Naranjo, quien recomendó optar por alimentos lo más naturales posibles, evitando los productos ultraprocesados.
“Una dieta rica en fibra insoluble es ideal, y es fundamental reducir la ingesta de azúcar. Aunque es difícil eliminarla por completo, es preferible consumir alimentos azucarados durante las comidas y no entre ellas. También se sugiere preferir frutos secos, frutas y verduras”, planteó.
Hábitos alimenticios.
A largo plazo, los hábitos alimenticios juegan un papel crucial en la salud bucal. Cuidar la alimentación es una de las principales herramientas para evitar caries y mantener una buena salud dental.
“Esto puede compararse con una inversión en salud: cuidar la dieta hoy, permitirá tener una mejor calidad de vida en el futuro”, señaló el odontólogo, quien agregó que de ser necesario se debe buscar asesoría para mejorar los hábitos alimenticios.
“Mantener controles regulares con el dentista y evaluar periódicamente los hábitos alimenticios no solo ayuda a prevenir problemas dentales, sino que también contribuye al bienestar general del cuerpo. Si algo le hace bien o mal a tus dientes, también le hace bien o mal al resto del cuerpo”, precisó.
Otro aspecto a considerar es el consumo de agua, especialmente en regiones de Chile donde el agua está fluorada, lo que es altamente beneficioso. “El flúor ayuda a fortalecer la estructura del esmalte y reduce el riesgo de caries”.
También te puede interesar
Investigación busca devolver la vida a suelo degradado con el uso de microorganismos.
9 de octubre de 2025
ELECCIONES MUNICIPALES Y REGIONALES 2024: Seguridad de urnas y salas paso a paso.
26 de octubre de 2024
INVITACIÓN: Disfruta de la exposición gratuita “Rostros de Mujeres en la Historia de Chile”
14 de mayo de 2025